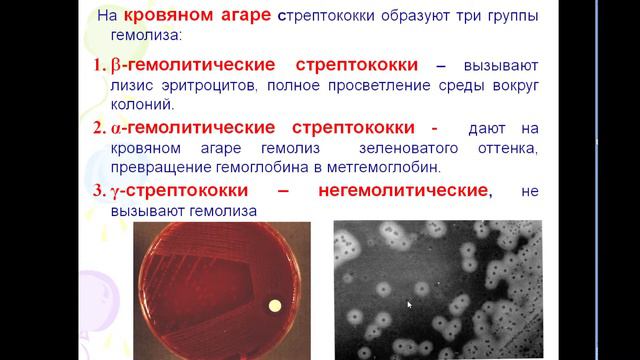

Автор / Канал: Любящий душа Страница 11
12.00 патогенные кокки

Потайной вход в бункер как построить

Ultimate Vegetable Grow Guide (Free Downloads) (pt 6)

Кратко даю информацию про возможность зарабатывания

Линии поддержки и сопротивления

МЕМЕ «134 статья»

World of Tanks открытие контейнеров путь воина

Erasmus+ How to write a project (Problem tree)

Шутки по телефону

Андрей Басов в Battlefield 3

Дом 122м2 на участке 4 сотки. Ростовское шоссе. Краснодар. #купитьдомвкраснодаре #константинанохин

Что случилось я попал в какую-то не понятную игру

Vector of Underground - Mishka!

GOLU PAYAL NE LIYA DAIMOND KA PURSE | FAMILY FITNESS

Бун Дуб - История Канала! Почему Его Заблокировали?

FRITTATA semplice, facile e veloce

мой говарящий том: ухаживаю за ним

How To Remove Shortcut Virus From PC/Laptop/Pen-drive

MRBEAST 5 ЛЕТ НАЗАД!

How to Use Ctrl + J keyboard shortcut key with Practical | Ctrl + J = Justify Text in Urdu & Hindi

Самурайский конь и не такое умеет :)))

Easy School глазами студентов

Существует ли нормальная реальность? Психолог Марина Линдхолм

ПЕРВЫЕ КРУТКИ ГЕНЕРАЛА|ЦЗИН ЮАНЬ ЧТО ТЫ ТВОРИШЬ?!HONKAI:STAR RAIL
За каждым успешным каналом стоит личность, идея и сотни часов кропотливого труда. Если вы здесь, значит, автор «Любящий душа» уже сумел зацепить ваше внимание своим уникальным стилем или подачей. А мы на RUVIDEO позаботились о том, чтобы вы могли изучить весь архив его работ в максимально комфортных условиях — без лишней суеты и преград.
Почему за работами канала «Любящий душа» так интересно наблюдать? Всё просто: это честный контент, который находит отклик в сердцах зрителей. На нашем ресурсе вы можете смотреть онлайн все видео любимого автора бесплатно и в хорошем качестве. Нам важно, чтобы вы видели каждую деталь и слышали каждый нюанс, поэтому мы используем только стабильные плееры из открытых источников Rutube.
Следите за новинками канала, пересматривайте старые шедевры и открывайте для себя новые грани творчества «Любящий душа». Мы постоянно обновляем ленту, чтобы у вас под рукой всегда были самые свежие выпуски. Никаких сложных регистраций — только вы и творчество, которое вдохновляет. Приятного вам путешествия по миру авторского контента на RUVIDEO!
Видео взято из открытых источников Rutube. Если вы правообладатель, обратитесь к первоисточнику.